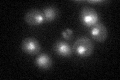
YGR270W
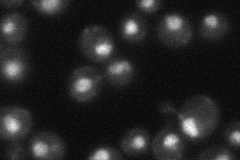
YGR270W
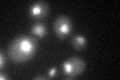
YGR270W
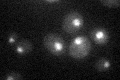
YGR270W

View description
Protein that localizes to chromatin and has a role in regulation of histone gene expression; has a bromodomain-like region that interacts with the N-terminal tail of histone H3, and an ATPase domain; potentially phosphorylated by Cdc28p
Localization:
Intensity:
Fold change:
Significance:
-
C’ GFP library in SD
nucleus28.44 -
N' NOP1pr-GFP in SD

nucleus88.9293 -
N' TEF2pr-mCherry in SD

nucleus104.437 -
N' NATIVEpr-GFP in SD
cell periphery,nucleus36.7586 -
N' TEF2pr-VC and Cyto-VN in SD

punctate,nucleus38.4052 -
C’ GFP library in SD+DTT
nucleus22.470.78No -
C’ GFP library in SD+H2O2

nucleus31.181.09No -
C’ GFP library in Starvation Media
nucleus24.970.87No -
C’ GFP library on the background of Pup2-DaMP

nucleus -
C’ GFP library on the background of CCT mutant

nucleus24.76350.870379No
